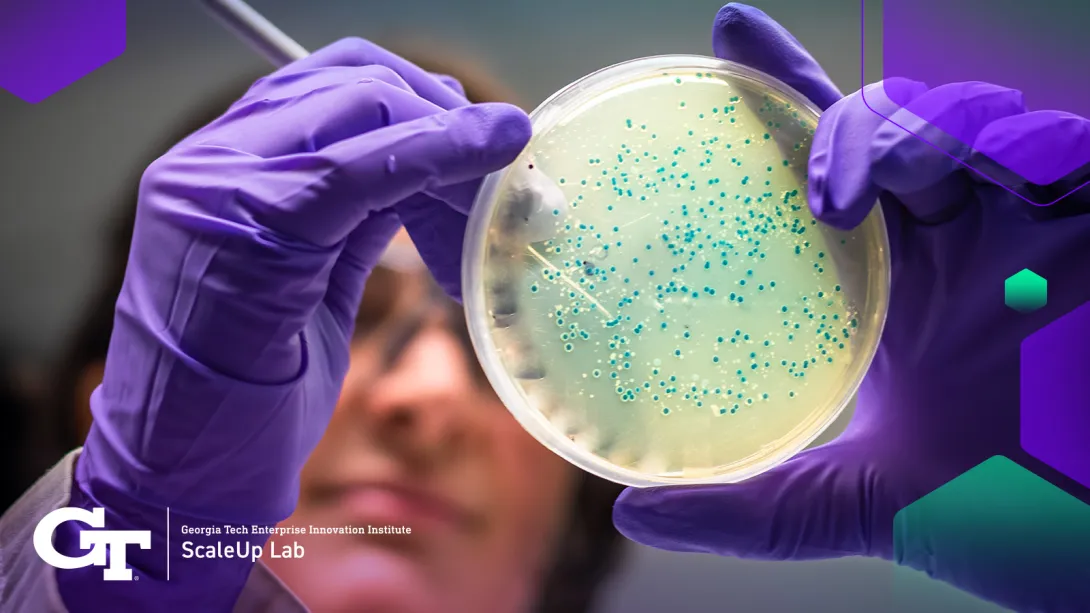
petri dish

Microbial engineering, an interdisciplinary field at the intersection of microbiology, genetics, and engineering, has emerged as a powerful tool for addressing pressing global challenges. By manipulating the genetic makeup of microorganisms, scientists can harness their unique abilities for environmental remediation, sustainable manufacturing, and advancements in healthcare. This comprehensive overview delves into the applications, methods, and implications of microbial engineering, highlighting its potential to revolutionize various sectors while reflecting on future directions.
1. Understanding Microbial Engineering: Microbial engineering involves the modification of microorganisms at the genetic level to enhance or introduce specific traits. These traits can include increased tolerance to environmental stressors, enhanced metabolic capabilities, or the production of valuable compounds. Key components of microbial engineering include genetic modification techniques such as gene editing, synthetic biology, and metabolic engineering.
2. Environmental Remediation: Microbial engineering holds immense promise for mitigating environmental pollution and restoring ecosystems. Microbes can be engineered to degrade pollutants, such as hydrocarbons, heavy metals, and pesticides, through processes like bioremediation and phytoremediation. Engineered microorganisms can also be deployed to treat wastewater, purify soil, and remediate contaminated sites, offering sustainable solutions to environmental challenges.
3. Sustainable Manufacturing: In the realm of sustainable manufacturing, microbial engineering enables the production of bio-based materials, chemicals, and fuels using renewable resources. By optimizing microbial metabolism, researchers can design microorganisms capable of converting biomass, such as agricultural waste or algae, into high-value products. This approach reduces reliance on fossil fuels, minimizes carbon emissions, and fosters a circular economy model.
4. Healthcare Applications: Microbial engineering is revolutionizing healthcare by facilitating the development of novel therapeutics, vaccines, and diagnostic tools. Engineered microbes can be used to produce pharmaceuticals, enzymes, and biologics with precision and scalability. Moreover, probiotics engineered to deliver therapeutic payloads offer targeted treatments for various diseases, while synthetic biology approaches enable the design of living diagnostics for rapid disease detection.
5. Challenges and Ethical Considerations: Despite its tremendous potential, microbial engineering faces several challenges and ethical considerations. Concerns regarding biosafety, biosecurity, and unintended ecological consequences necessitate robust regulatory frameworks and risk assessment protocols. Furthermore, questions surrounding intellectual property rights, equity in access to technology, and the potential misuse of engineered microbes underscore the need for ethical guidelines and public engagement.
6. Future Directions and Reflections: Looking ahead, the field of microbial engineering is poised for rapid growth and innovation. Advances in gene editing technologies, such as CRISPR-Cas systems, will enhance the precision and efficiency of microbial manipulation. Additionally, interdisciplinary collaboration between scientists, engineers, policymakers, and stakeholders will drive the development of sustainable solutions and ensure the responsible deployment of microbial technologies. As we navigate the complexities of harnessing microbial power, it is essential to prioritize transparency, equity, and sustainability to realize the full potential of microbial engineering for the benefit of society and the environment.
Conclusion: Microbial engineering represents a paradigm shift in our approach to addressing global challenges across environmental, manufacturing, and healthcare domains. By leveraging the natural capabilities of microorganisms and augmenting them through genetic engineering, we can develop innovative solutions that are sustainable, cost-effective, and scalable. However, realizing the full potential of microbial engineering requires careful consideration of ethical, regulatory, and societal implications. As we embark on this transformative journey, collaboration, responsible innovation, and a commitment to sustainability will be key to shaping a future where microbes play a central role in building a healthier, more resilient planet.